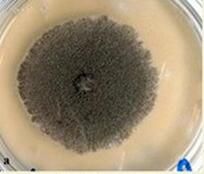
塔賓麴黴菌 塔賓麴黴菌

發現
在液體MSM(2%葡萄糖)中孵育了三周的PU表面上的塔賓麴黴菌命名
此次中科院研究組從城市垃圾中分離出的用於降解塑膠的新型真菌,被鑑定命名為“塔賓麴黴菌”。
研究
研究指出,在“塔賓麴黴菌”作用下,原本在自然環境中難以降解的塑膠,兩周就可以明顯看到生物降解過程,兩個月後其培養基上的塑膠聚合物基本消失。
塔賓麴黴菌是2017年發現的一種新型真菌,該真菌能夠高效降解聚氨酯塑膠,有望成為未來治理白色污染的“利器”。
在液體MSM(2%葡萄糖)中孵育了三周的PU表面上的塔賓麴黴菌此次中科院研究組從城市垃圾中分離出的用於降解塑膠的新型真菌,被鑑定命名為“塔賓麴黴菌”。
研究指出,在“塔賓麴黴菌”作用下,原本在自然環境中難以降解的塑膠,兩周就可以明顯看到生物降解過程,兩個月後其培養基上的塑膠聚合物基本消失。
梁武帝記載曲阿酒的傳說丹陽黃酒在古代亦稱曲阿酒,因其質地晶瑩,鮮甜醇香,風格獨異而名聲遠播。翻開《辭源》可找到“曲阿酒...曲阿湖,故曲阿酒美也。”這段文字為曲阿酒美找到了神奇的“根據”。儘管...
動畫] 劇集信息各話目錄第一季: 曲序 日文標題 中文標題 日本播出日期...
劇情簡介 角色介紹 動畫製作 劇集信息 動畫音樂動畫] 劇集信息各話目錄第一季: 曲序 日文標題 中文標題 日本播出日期...
劇情簡介 角色介紹 動畫製作 劇集信息 動畫音樂導演 戈爾·維賓斯基 副導演(助理) Steven F....導演(提名) 戈爾·維賓斯基 Gore Verbinski 最佳特效...——黑珍珠號的詛咒導演:戈爾·維賓斯基 Gore Verbinski 編 劇...
劇情簡介 演職員表 音樂原聲 獲獎記錄 加勒比海盜1毛茛鹼白蓬草長品白砒白前甙B白屈菜賓白屈菜赤鹼白屈菜紅鹼白屈菜紅鹼甲醇化物...素毒蕈氨毒蕈鹼毒藜素犢肌胺獨腳金醇杜巴胺杜賓定杜賓寧杜鵑毒素杜鵑花醇苷...
厚殼烯酮內酯 相關知識基本資料又名: 《魔法小米路》作者: 筱冢廣夢類別: 奇幻作者簡介筱冢廣夢:1979年3月27日 -)是日本少女漫畫家,...
基本資料 作者簡介 名片 簡介 角色介紹劇情簡介 天蠍 聯邦探員凱布 ( 羅伯特·派屈克 飾)曾和沃特打過交道,他找到沃特,召集天蠍團隊並利用他們廣泛的科技知識來解決...
劇情簡介 分集劇情 演員表 角色介紹 音樂原聲玲,王娜,梁軍艷等赤鐵礦及孔雀石對桐油和大漆老化性能的影響雷勇,曲亮,成...
期刊簡介 辦刊宗旨 主要欄目 參考論題 來稿注意事項